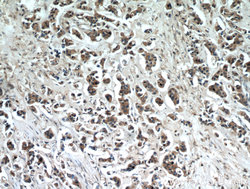

Antibody data
- Antibody Data
- Antigen structure
- References [0]
- Comments [0]
- Validations
- Western blot [1]
- Immunocytochemistry [1]
- Immunohistochemistry [2]
Submit
Validation data
Reference
Comment
Report error
- Product number
- 21323-1-AP - Provider product page

- Provider
- Proteintech Group
- Proper citation
- Proteintech Cat#21323-1-AP, RRID:AB_10733645
- Product name
- TTC39A antibody
- Antibody type
- Polyclonal
- Description
- TTC39A antibody (Cat. #21323-1-AP) is a rabbit polyclonal antibody that shows reactivity with human, mouse, rat and has been validated for the following applications: IF, IHC, WB,ELISA.
- Reactivity
- Human, Mouse, Rat
- Host
- Rabbit
- Conjugate
- Unconjugated
- Isotype
- IgG
- Vial size
- 20ul, 150ul
No comments: Submit comment
Supportive validation
- Submitted by
- Proteintech Group (provider)
- Main image

- Experimental details
- mouse liver tissue were subjected to SDS PAGE followed by western blot with 21323-1-AP(TTC39A antibody) at dilution of 1:100
- Sample type
- tissue
Supportive validation
- Submitted by
- Proteintech Group (provider)
- Main image

- Experimental details
- Immunofluorescent analysis of HepG2 cells, using TTC39A antibody 21323-1-AP at 1:25 dilution and Rhodamine-labeled goat anti-rabbit IgG (red). Blue pseudocolor = DAPI (fluorescent DNA dye).
- Sample type
- cell line
Supportive validation
- Submitted by
- Proteintech Group (provider)
- Main image

- Experimental details
- Immunohistochemical of paraffin-embedded human breast cancer using 21323-1-AP(TTC39A antibody) at dilution of 1:50 (under 40x lens)
- Sample type
- tissue
- Submitted by
- Proteintech Group (provider)
- Main image
- Experimental details
- Immunohistochemical of paraffin-embedded human breast cancer using 21323-1-AP(TTC39A antibody) at dilution of 1:50 (under 10x lens)
- Sample type
- tissue